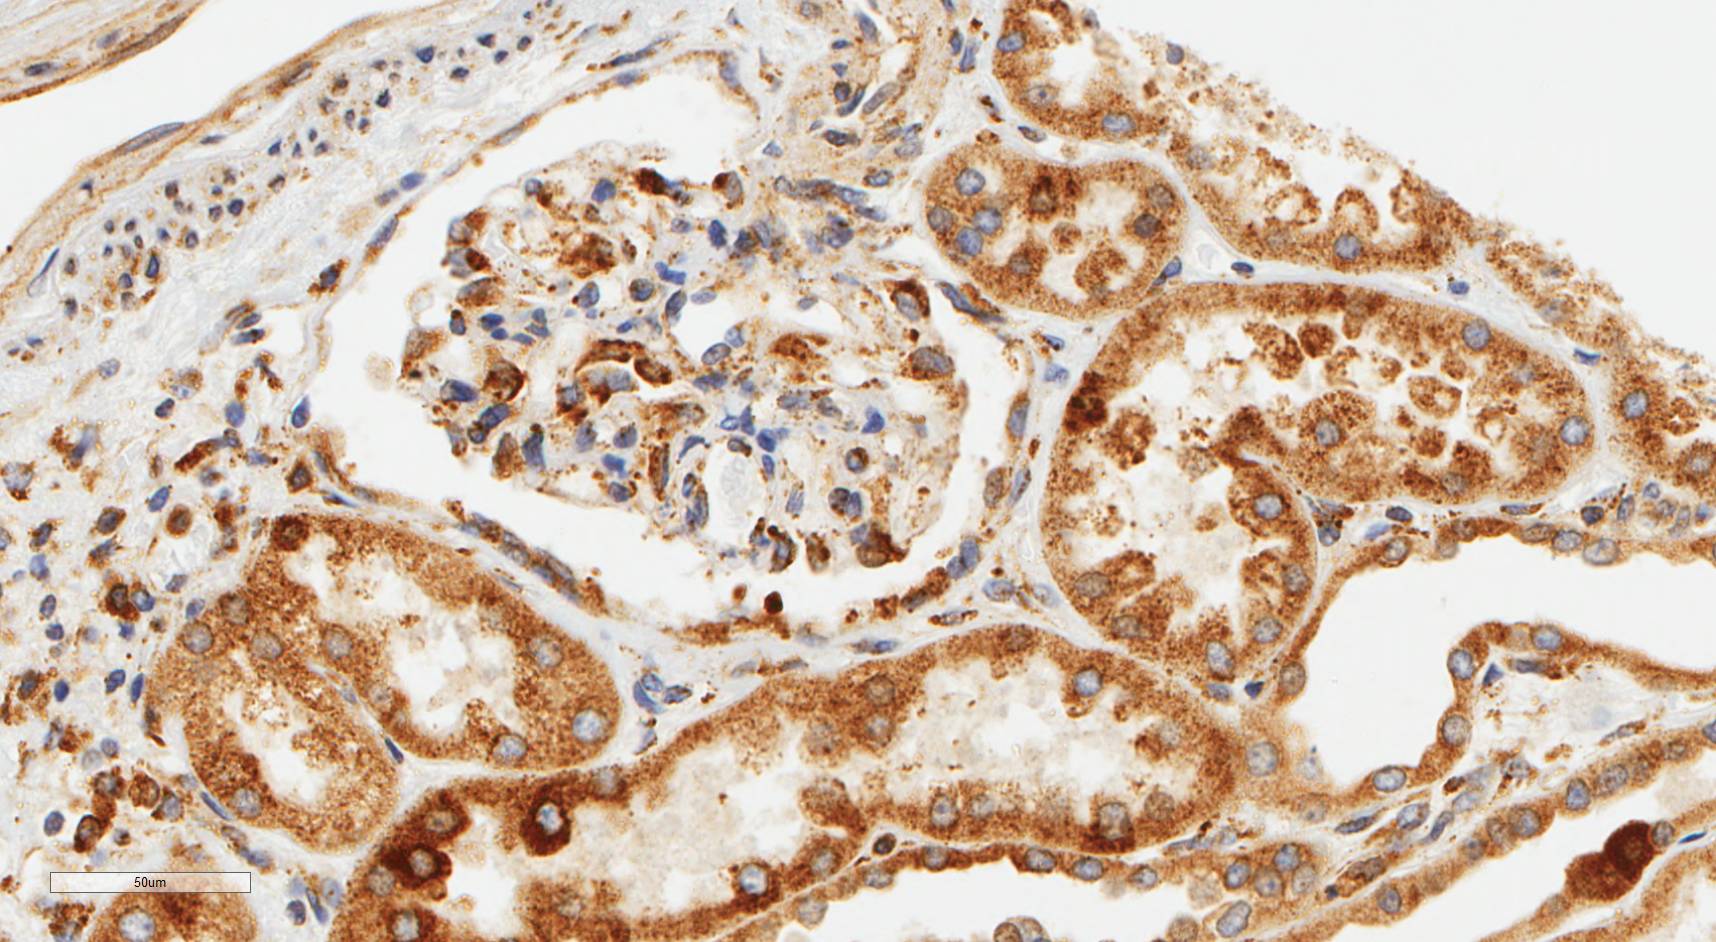
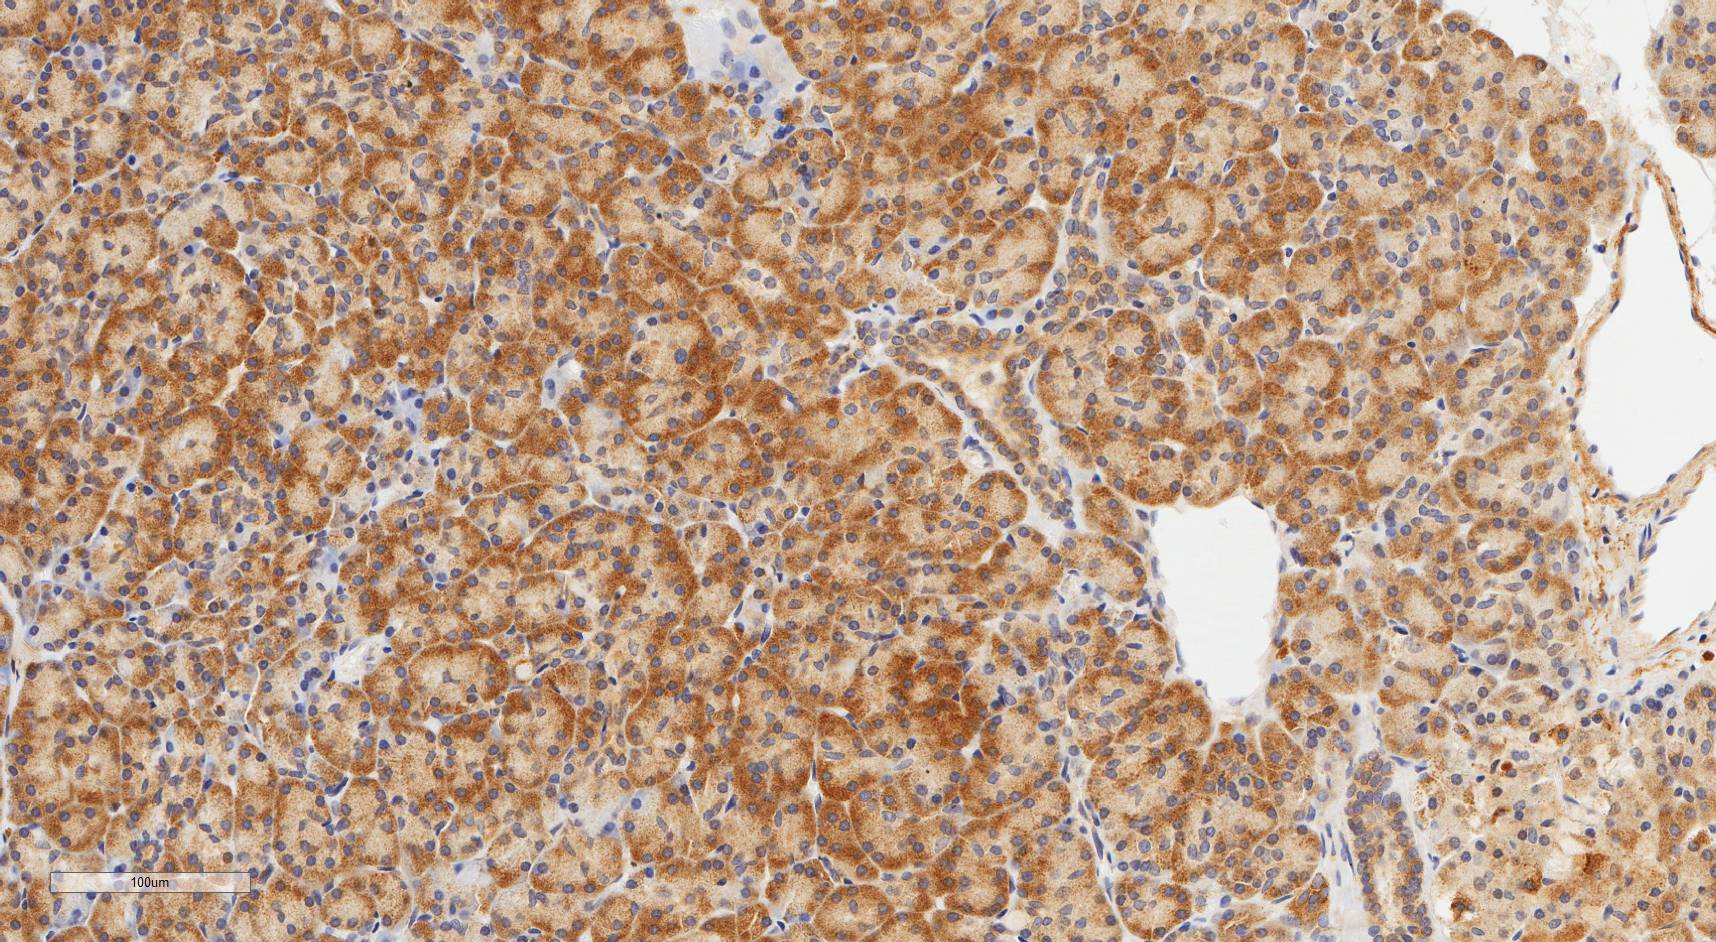
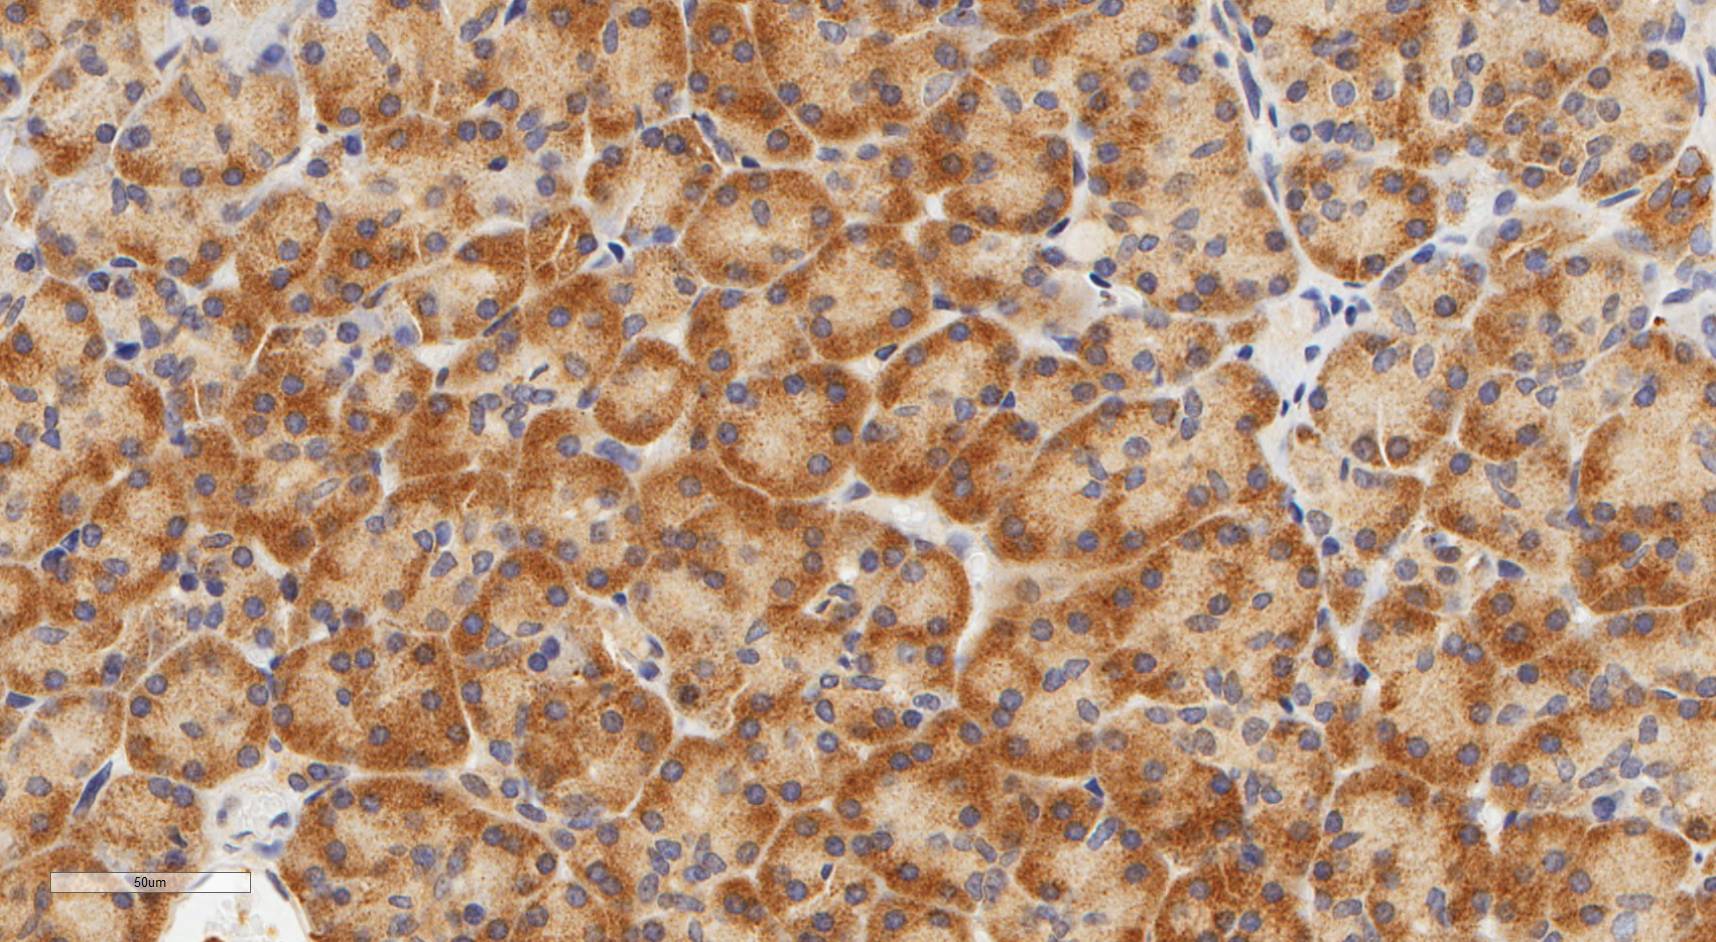
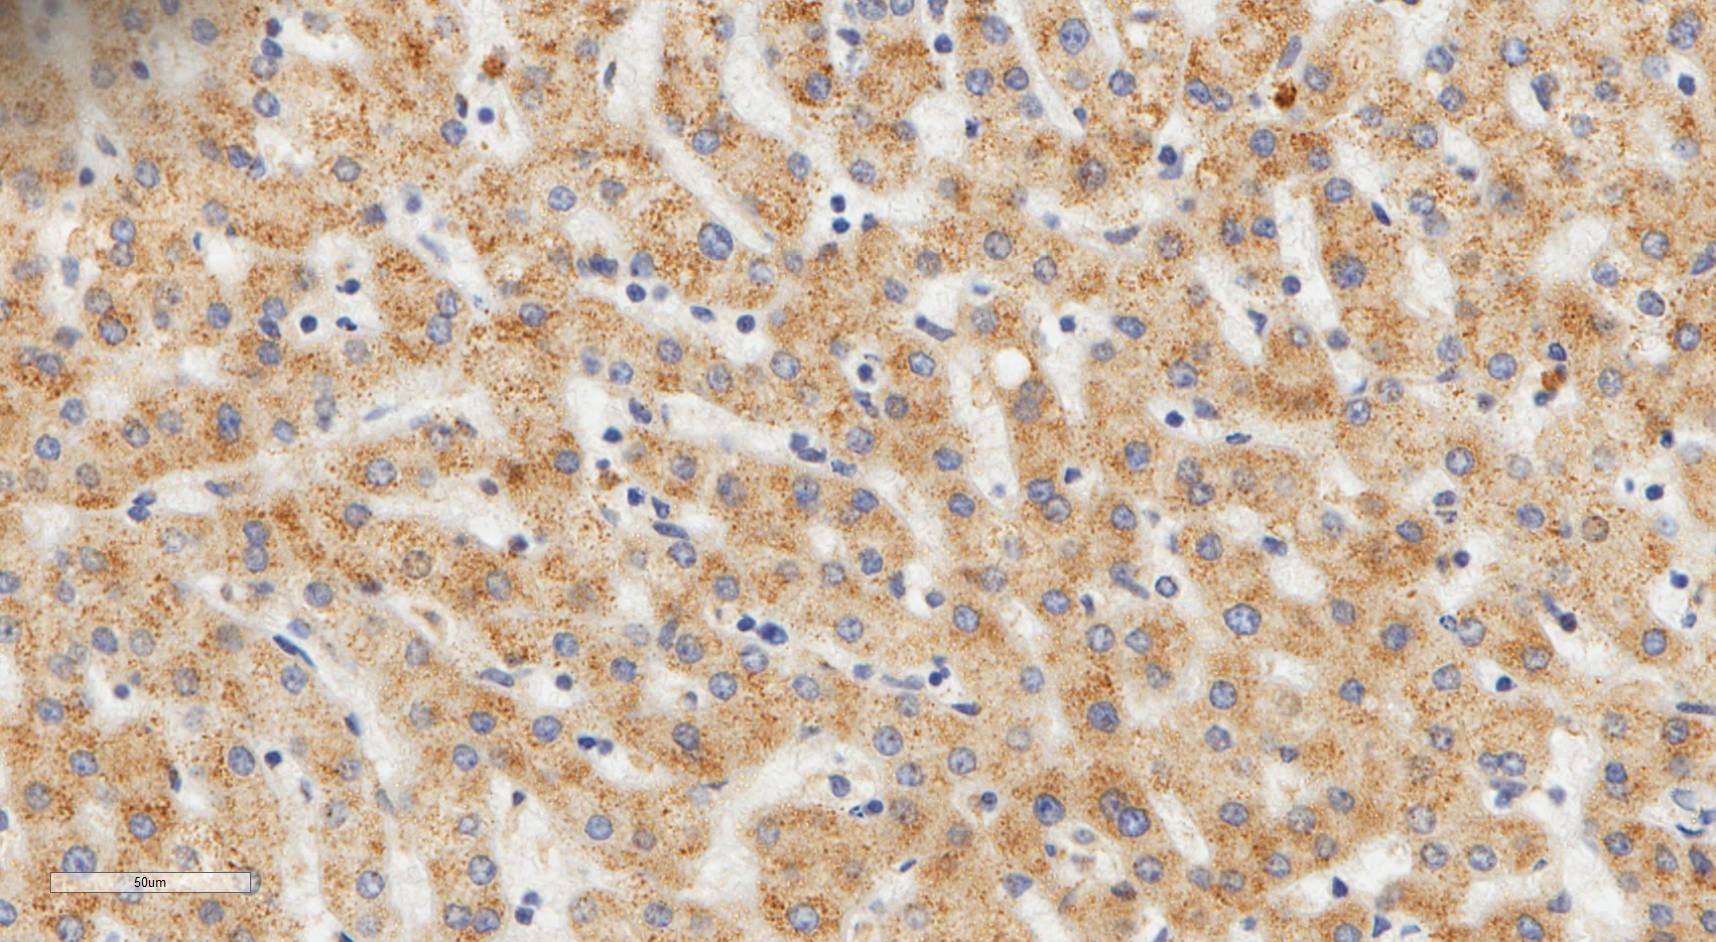
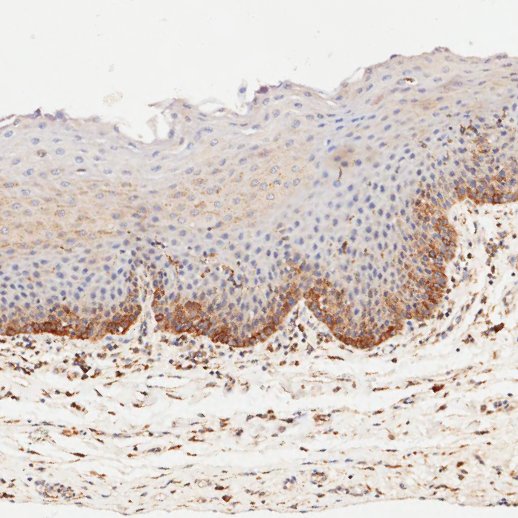
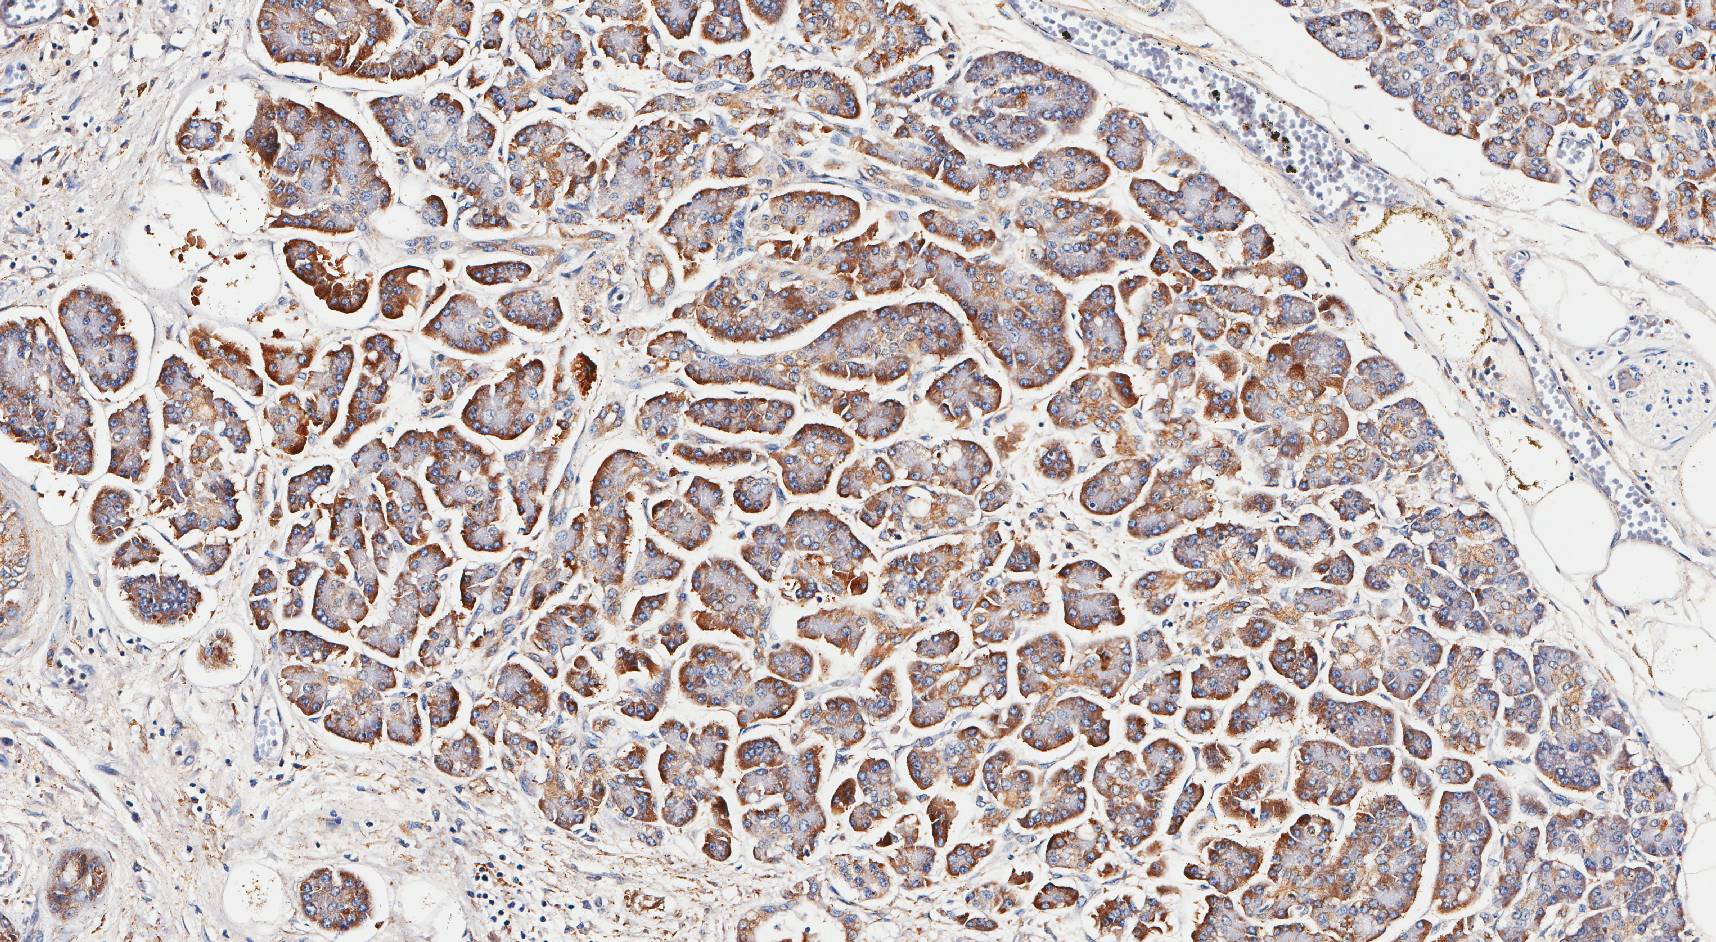

Laminin N terminus alpha31 (LaNt a31) is a really interesting laminin-related protein that the Hamill lab has been investigating for a while. Until recently, our studies focused entirely on the epithelial tissues of the skin, the surface of the eye and oral squamous cell carcinoma. However, we’ve always known that this relatively unstudied protein is also expressed by other tissues. As a first (and really important) step to understanding what this protein’s role is in tissue function, we used our new mouse monoclonal antibodies against the human form of LaNt a31 to screen a wide-range of human tissues.
Below you can see some of our favourite images from the selection. Click on an image to view as a slideshow.
You can see the whole story in the paper by Lee Troughton et al., available here.

Tissue section staining is really just the start of this story. If you are intrigued by anything you see here, feel free to reach out.
Like cool science pics? You will also enjoy our collections of cool pics…
